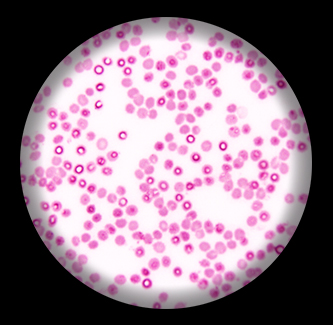

คำอธิบาย
อาณาจักรสัตว์ (Animal Kingdom)
สไลด์ถาวร เซลล์เม็ดเลือดคน (Human Blood Smear; Wright stain)
Biolab : (BL) สไลด์ถาวรคุณภาพสูงเห็นโครงสร้างของเซลล์ชัดเจนด้วยเทคนิคการย้อมสีที่ได้คุณภาพมาตราฐานสากล
BS : สไลด์ถาวรคุณภาพดี มีเซลล์พื้นฐานของอาณาจักรพืชและอาณาจักรสัตว์
ดู สไลด์ถาวร อื่นๆ https://intereducation.co.th/product-category/permanent-slide/slide/animal-slide/
Facebook: https://www.facebook.com/intered.th
Youtube: https://www.youtube.com/@intereducationchannel